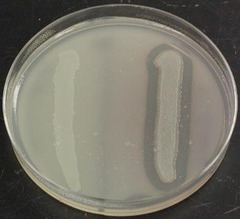
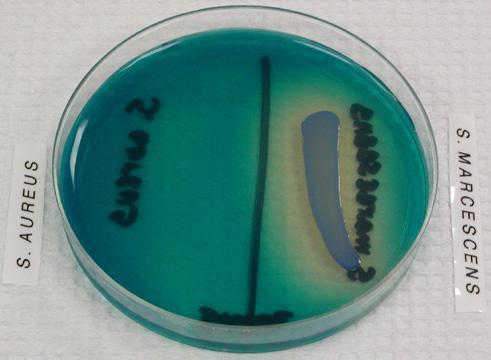

Skim Milk Agar
Substrate: Casein
Enzyme: Casease
Product: Amino Acids
Positive Appearance: Clearing
Positive Bacteria: Bacillus
Tributyrin Agar
Substrate: Triglyceride
Enzyme: Lipase
Product: Glycerol, Fatty Acids
Positive Appearance: Clearing
Positive Appearance:
Staphylococus aureus
Serratia marcescans
Enterococcus
Gelatin Agar
Substrate: Collagen
Enzyme: Gelatinase
Product: Amino Acids
Positive Appearance: Liquid
Positive Bacteria: Bacillus
Starch Agar
Substrate: Starch
Enzyme: Amylase
Product: Maltose
Reagent: Iodine
Positive Appearance: Purple w/ Iodine
Iodine binds starch
CLEARING is positivePositive Bacteria: Bacillus
DNA Agar
Methyl Green as a pH indicator
Substrate- DNA
Enzyme- DNAase
Product- Nucleotides
Positive Appearance- Clearing
Positive Bacteria- Serratia
Phenol Red
Carbohydrate Broth
phenol red- pH indicator
durham tube to show gas
Substrate- Glucose, Lactose, Sucrose
no enzyme specified
Product- Acid Fermentation- Yellow
Alkaline Fermentation- Red
Gas- CO<sub>2</sub>or H<sub>2</sub> - BubblesPositive Bacterium:
E. Coli- Yellow and Gas in Glucose and Lactose
Red and no Gas in Sucrose
Staph aureus and Enterococcus- Yellow and no Gas in all
Pseudomonas- Red and no Gas in allMethyl Red
Substrate- Pyruvate
Enzyme- Not specified
Product- Acid Fermentation
Positive Appearance- Red
Positive Bacteria- E coli
Voge’s Proskaurer
Substrate- Pyruvate
enzyme not specified
Product- Acetoin
Reagent- Barritt’s A B and Creatine
Positive Appearance- Red across top
Positive Bacteria- Enterobacter
SIM test
Sulfate
Indole
Motility
Sulfite Test
Substrate- Peptone iron
enzyme not specified
Product- H2S
Positive Appearance- Black
Positive Bacteria- Salmonella
Proteus
Indole Test
Substrate- Tryptophan
enzyme not specified
Product- Indole
Reagent- Kovac’s
Positive Appearance- Red
Positive Bacteria- E. coli
Motility Test
No Substrate, Enzyme or Product
Positive appearance- cloudy around stab
Positive bacteria- E coli
Enterobacter
Simmon’s Citrate Test
bromthymol blue- ph indicator
Substrate- Sodium citrate
Enzyme not specified
Product- Ammonia
Positive Appearance- Blue (alkaline)
Positive Bacteria- Enterobacter
Klebsiella
Pseudomonas
CitrobacterNitrate reduction
Substrate- Nitrate
Enzyme- Nitrite and nitrite reductase
Product- Nitrite and Ammonia or N2
Positive Appearance-
Nitrite- E coli- Red with Nitrate A and B Ammonia or N<sub>2-</sub> Pseudomonas NO COLOR No product- Enterococcus Red with zinc
Triple Sugar Iron
phenol red- pH indicator
Substrate- Glucose, Lactose, Sucrose
Enzyme not specified
Urea Test
Substrate- Urea
Enzyme- Urease
Product- Ammonia, CO2
Positive Appearance- Pink (alkaline)
Positive Bacteria- Proteus
Decarboxylation
Substrate- Lysine, Arginine, Ornithine
Enzyme- Decarboxylase
Product- Removes acid group from amino acids
3/8” mineral oil to create anaerobic environment
Positive Appearance- Purple
Enterobacter- Positive for Lysine
Positive for Ornithine
Klebsiella- Negative for Ornithine
Deamination
Substrate- Phenylalanine
Enzyme- Deaminase
Product- Removes amino group
Reagent- Ferric chloride
Positive appearance- Green
Positive bacteria- Proteus
Skim milk agar

Gelatin agar

Starch agar
DNA agar

Phenol Red Test

Methyl Red